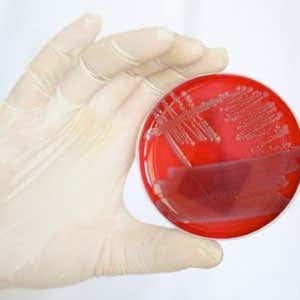

Una maxi insalata Made in Italy e una tabella antipanico per le famiglie. Anche a Monza la Coldiretti di Milano e Lodi scende in campo contro la psicosi del batterio killer. Giovedì 9 giugno 2011, presso il farmers' market di viale Romagna gli agricoltori di Campagna Amica prepareranno grandi insalate miste con cetrioli e pomodori da mangiare in pubblico e da offrire ai consumatori.
Una maxi insalata Made in Italy e una tabella antipanico per le famiglie. Anche a Monza la Coldiretti di Milano e Lodi scende in campo contro la psicosi del batterio killer. Giovedì 9 giugno 2011, presso il farmers' market di viale Romagna gli agricoltori di Campagna Amica prepareranno grandi insalate miste con cetrioli e pomodori da mangiare in pubblico e da offrire ai consumatori.
Alle 11 anche una delegazione di 20 rappresentanti politici provinciali e comunali, guidati dal presidente della Provincia di Monza e Brianza Dario Allevi parteciperà all'iniziativa e mangerà cetrioli e pomodori per dimostrare che non c'è nulla da temere, soprattutto se si scelgono prodotti italiani e se si seguono alcune elementari regole di buonsenso.
Per aiutare i consumatori la Coldiretti distribuirà, a Monza, la 'tabella anti panico” con suggerimenti e notizie sul batterio e sulle principali norme di buonsenso per una tranquilla igiene alimentare domestica.
«Per combattere la paura servono la massima trasparenza sui prodotti e un po' di buonsenso - spiega Carlo Franciosi, presidente della Coldiretti di Milano e Lodi - per questo stiamo organizzando una serie di iniziative di sensibilizzazione sul territorio per spiegare alla gente che con i prodotti italiani, come ha confermato lo stesso ministro della Sanità, non c'è nulla da temere. La presenza dell'indicazione d'origine, che purtroppo non è stata ancora estesa dall'Europa a tutto il settore agroalimentare, rappresenta una buona arma nelle mani dei consumatori per fare scelte serene e consapevoli».
La "tabella anti panico"
- Il batterio ha colpito solo in Germania e nei paesi del nord Europa.
- In Germania non si è ancora capito quale ne sia l'origine e prima i cetrioli e poi i germogli di soia sono stati scagionati, le indagini delle autorità sanitarie tedesche sono ancora in corso.
- In Italia i controlli su frutta e verdura da parte delle Asl sono quotidiani dal campo alla tavola.
- Quando si compra frutta e verdura ricordarsi che chi vende è obbligato a indicare il Paese d'origine del prodotto, quindi verificare la provenienza e scegliere. Secondo la Coldiretti è meglio acquistare prodotti italiani e meglio ancora se direttamente dagli agricoltori negli spacci aziendali, nei farmers' market o nelle botteghe di Campagna Amica.
- Frutta e verdura devono essere conservate in frigo, in buste separate, meglio se di carta, in modo da evitare accumuli di umidità all'interno.
- Se si torna casa dopo una giornata passata al lavoro o sui mezzi pubblici ricordarsi che è buona norma sempre lavarsi le mani prima di toccare frutta o verdura in modo da non portare alla bocca germi presi nell'ambiente esterno.
- Frutta e verdura vanno sempre lavate e asciugate con attenzione in modo da garantire la massima igiene prima del consumo.
- Ricordarsi che la cottura rappresenta in ogni caso una buona profilassi antibatterica.
Articoli correlati:
Igiene e sicurezza contro i batteri L'importanza della disinfezione
Allarme batterio E.coli 417 milioni i danni all'agricoltura
Batterio E.coli, improbabile la contaminazione da letame
Batterio killer, germogli di soia 'assolti” dalle prime analisi in Germania
Batterio killer, paura in Europa Forse il più letale della storia
Batterio killer dei cetrioli Le mosse contro le tossinfezioni
Cetrioli-killer, 10 morti in Germania Nessun allarme per l'Italia